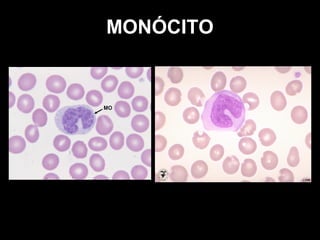
MONÓCITO

O documento descreve as principais células e órgãos do sistema imune. Detalha as células dendríticas, que reconhecem e apresentam antígenos para os linfócitos T, e as subpopulações mielóides e plasmocitóides. Também descreve os fagócitos mononucleares como macrófagos e monócitos, as células NK, os granulócitos como neutrófilos, mastócitos e basófilos, eosinófilos. Apresenta ainda os linfócitos T e B e

![CÉLULAS DENDRÍTICAS
•Caracterizada pela sua intensa capacidade fagocítica e por possuir longas
projeções de membrana
•Expressam grandes quantidades de receptores para padrões moleculares
associados a patógenos (PAMPs)]
•Apresentam como marcador celular CD11.
•Sua principal função é o reconhecimento inicial de antígenos, seu
processamento e apresentação para Linfócitos T](https://image.slidesharecdn.com/clulasetecidos-131031144549-phpapp01/85/ICSA17-Celulas-e-Tecidos-do-Sistema-Imune-2-320.jpg)